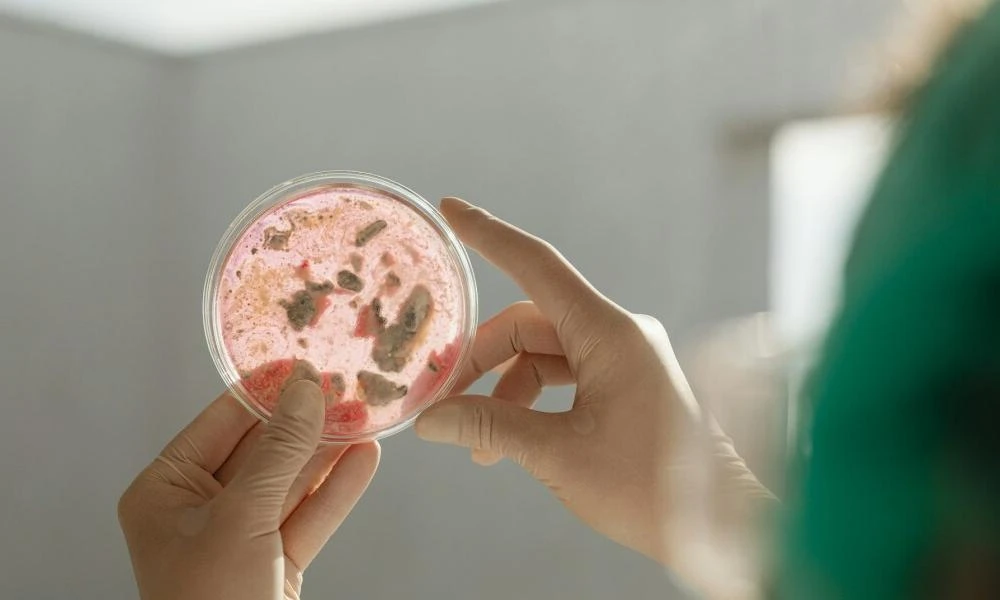
Αυτά είναι τα 8 πιο επικίνδυνα βακτήρια στον κόσμο

ΥΓΕΙΑ
-

Κίνδυνος καρδιαγγειακών παθήσεων: Νέα ανακάλυψη - Τι δείχνει το σχήμα της καρδιάς μας
Στην άμεση σύνδεση του σχήματος της καρδιάς με τον κίνδυνο εμφάνισης καρδιαγγειακών παθήσεων, όπως η αρρυθμία και η καρδιακή ανεπάρκεια, κατέληξε πρόσφατη έρευνα που δημοσιεύθηκε στο Nature Communicat...
Read More » -

Υγεία: Πως να αποφύγετε τις αναπνευστικές λοιμώξεις
Μπορεί να θεωρείται αυτονόητη η σύσταση για την υγεινή των χεριών, αλλά εξακολουθεί να εφαρμόζεται πλημμελώς- Ακολουθήστε τη σωστή ρουτίνα καθαριότητας των χεριών για να αποφύγετε αναπνευστικές λοιμώξ...
Read More » -
Αυτά είναι τα 8 πιο επικίνδυνα βακτήρια στον κόσμο
Εκατομμύρια άνθρωποι πεθαίνουν κάθε χρόνο από βακτηριακές λοιμώξεις, ακόμα και μετά από χρήση αντιβιοτικών. Αυτό συμβαίνει επειδή τα φάρμακα συχνά δεν είναι πλέον αποτελεσματικά, καθώς τα βακτήρια έχο...
Read More » -

Θα σημειωθεί έξαρση στα κρούσματα ιλαράς τους επόμενους μήνες-Ποιοι πρέπει να εμβολιαστούν
Mετά τις πιο πρόσφατες εκτιμήσεις του ΠΟΥ για τον μεγάλο κίνδυνο των ξεσπασμάτων ιλαράς, οι ειδικοί του Ευρωπαϊκού Κέντρου Ελέγχου Νοσημάτων (ECDC) κρούουν τον κώδωνα του κινδύνου για την έξαρση που α...
Read More » -

Υγεία: Η σύνδεση μεταξύ παχυσαρκίας και καρκίνου
Η παχυσαρκία, κυρίως η κλινικά σοβαρή μορφή της, είναι συνδεδεμένη με την εμφάνιση πολυάριθμων σοβαρών παθήσεων. Πιο αναλυτικά, η παχυσαρκία και ο καρκίνος είναι πια δύο έννοιες στενά συνδεδεμένες καθ...
Read More » -

Η διατροφή που προλαμβάνει τις επιθετικές μορφές του καρκίνου του προστάτη
Μια υγιεινή διατροφή μειώνει τον κίνδυνο εξέλιξης του πρώιμου καρκίνου του προστάτη όπως παρουσιάζει μελέτη με επικεφαλής το Johns Hopkins Medicine. Πιο συγκεκριμένα, τα ευρήματα της έρευνας, που δημο...
Read More » -

9 αποδεδειγμένοι τρόποι για να χάσετε βάρος χωρίς δίαιτα ή γυμναστική (Βίντεο)
Ο κόσμος της διατροφής και της απώλειας βάρους είναι γεμάτος με συμβουλές, προγράμματα και προγράμματα γυμναστικής που συχνά μπορεί να σας μπερδεύουν ή ακόμη και να σας παραπλανούν.Ευτυχώς υπάρχουν απ...
Read More » -

Άνοια: Από κόκκινο σε λευκό - Η διατροφική στροφή που σώζει
Η διατροφή που δίνει λύση στο «μυστήριο» της θεραπείας των αυτοάνοσων νοσημάτων Η Ρωσίδα γαστρεντερολόγος, διατροφολόγος και ψυχολόγος διατροφικής συμπεριφοράς Nuria Dianova ανέφερε ποιο κρέας μειώνε...
Read More » -

ΕΟΔΥ: Aνοίγει γραμμή βοήθειας για την μείωση του καπνίσματος
Γραμμή βοήθειας για τη διακοπή του καπνίσματος ενεργοποιεί το αμέσως επόμενο διάστημα ο ΕΟΔΥ, στο πλαίσιο μιας γενικότερης προσπάθειας να ελεγχθεί το κάπνισμα στην Ελλάδα, που αυτή τη στιγμή αγγίζει τ...
Read More » -

Καρκίνος προστάτη: Aνεπιθύμητες ενέργειες και επιπλοκές κατόπιν θεραπείας–Τι έδειξε μελέτη σε 4000 ασθενείς
Μελέτη που δημοσιεύθηκε πρόσφατα στο JAMA Oncology περιλάμβανε 3946 ασθενείς με καρκίνο προστάτη και εξέτασε τις μακροχρόνιες ανεπιθύμητες ενέργειες και επιπλοκές σχετικές με τη θεραπεία του καρκίνου ...
Read More »
